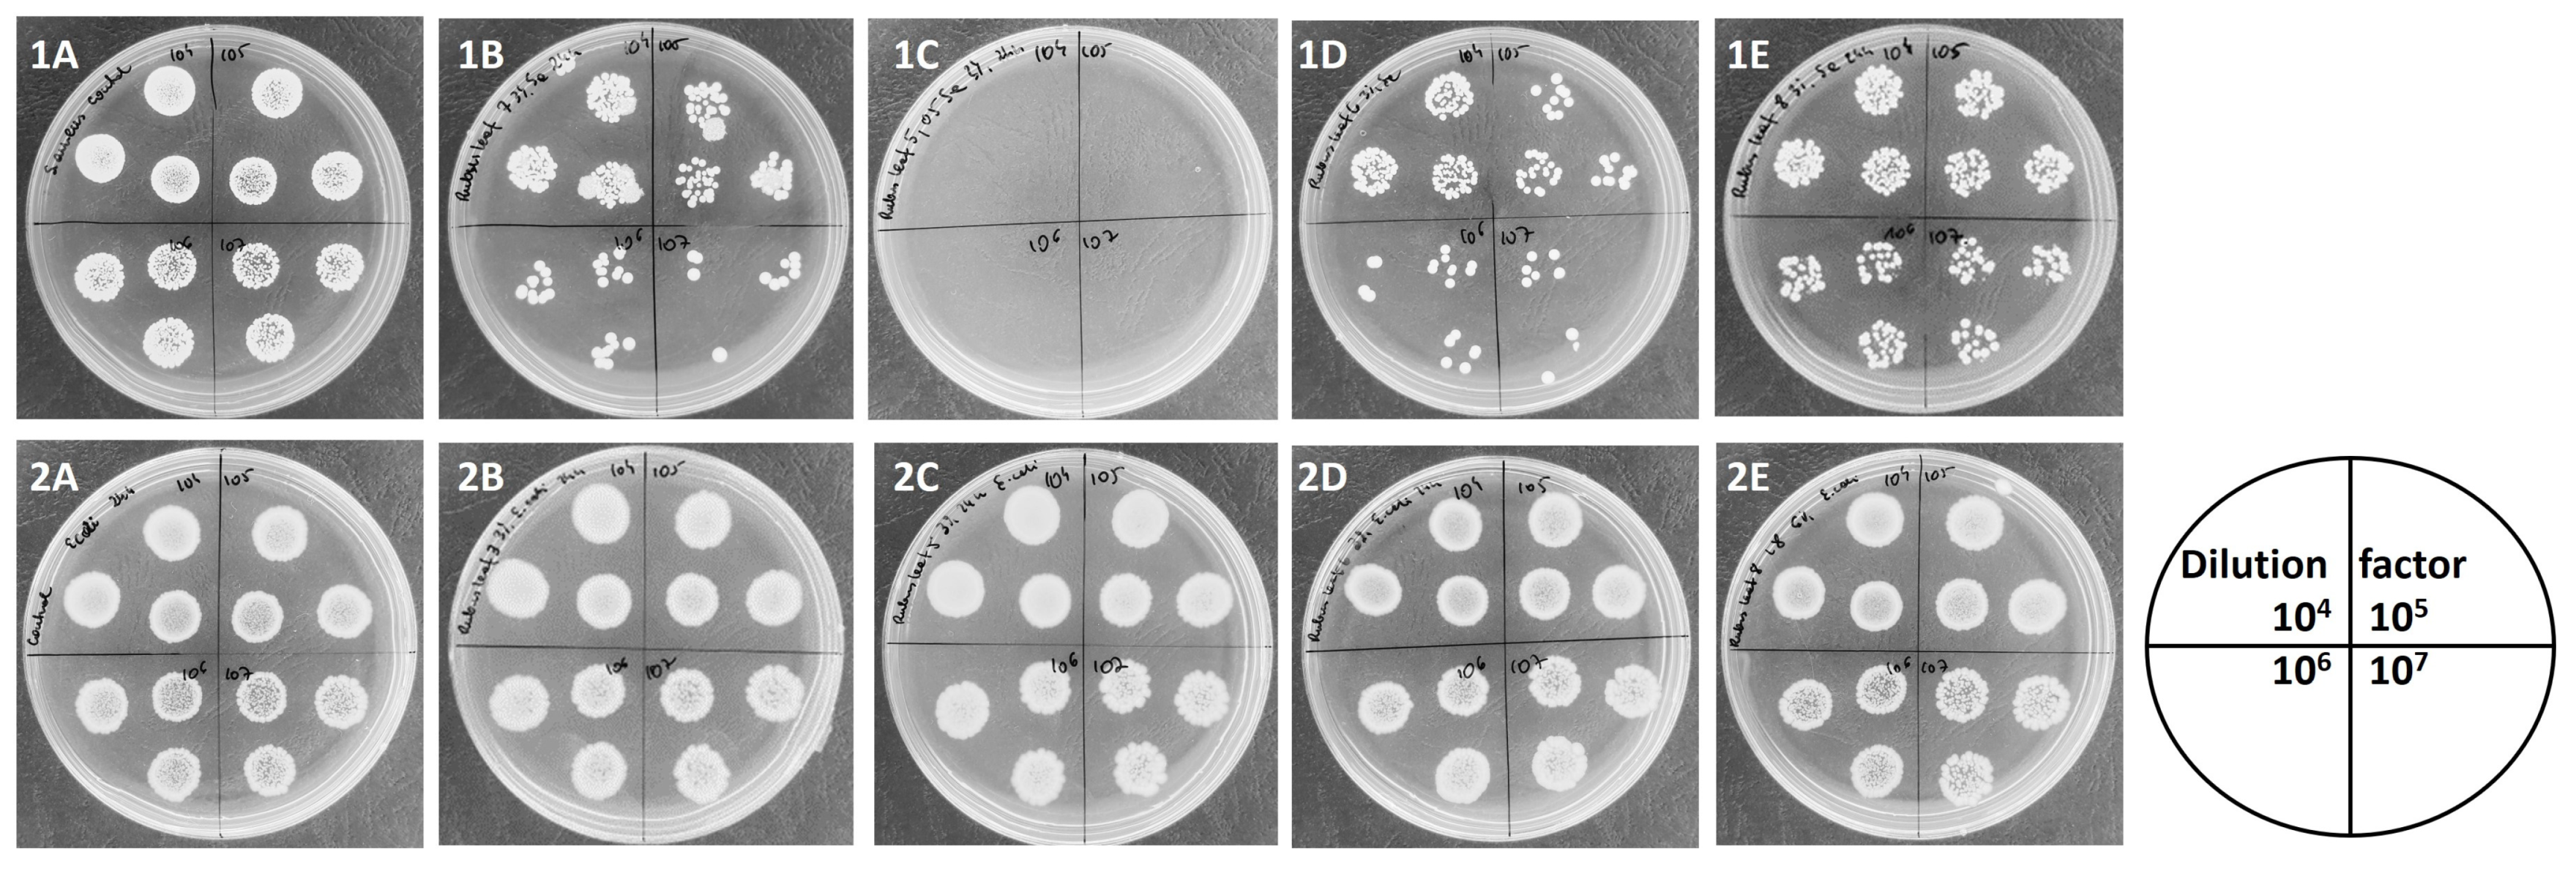
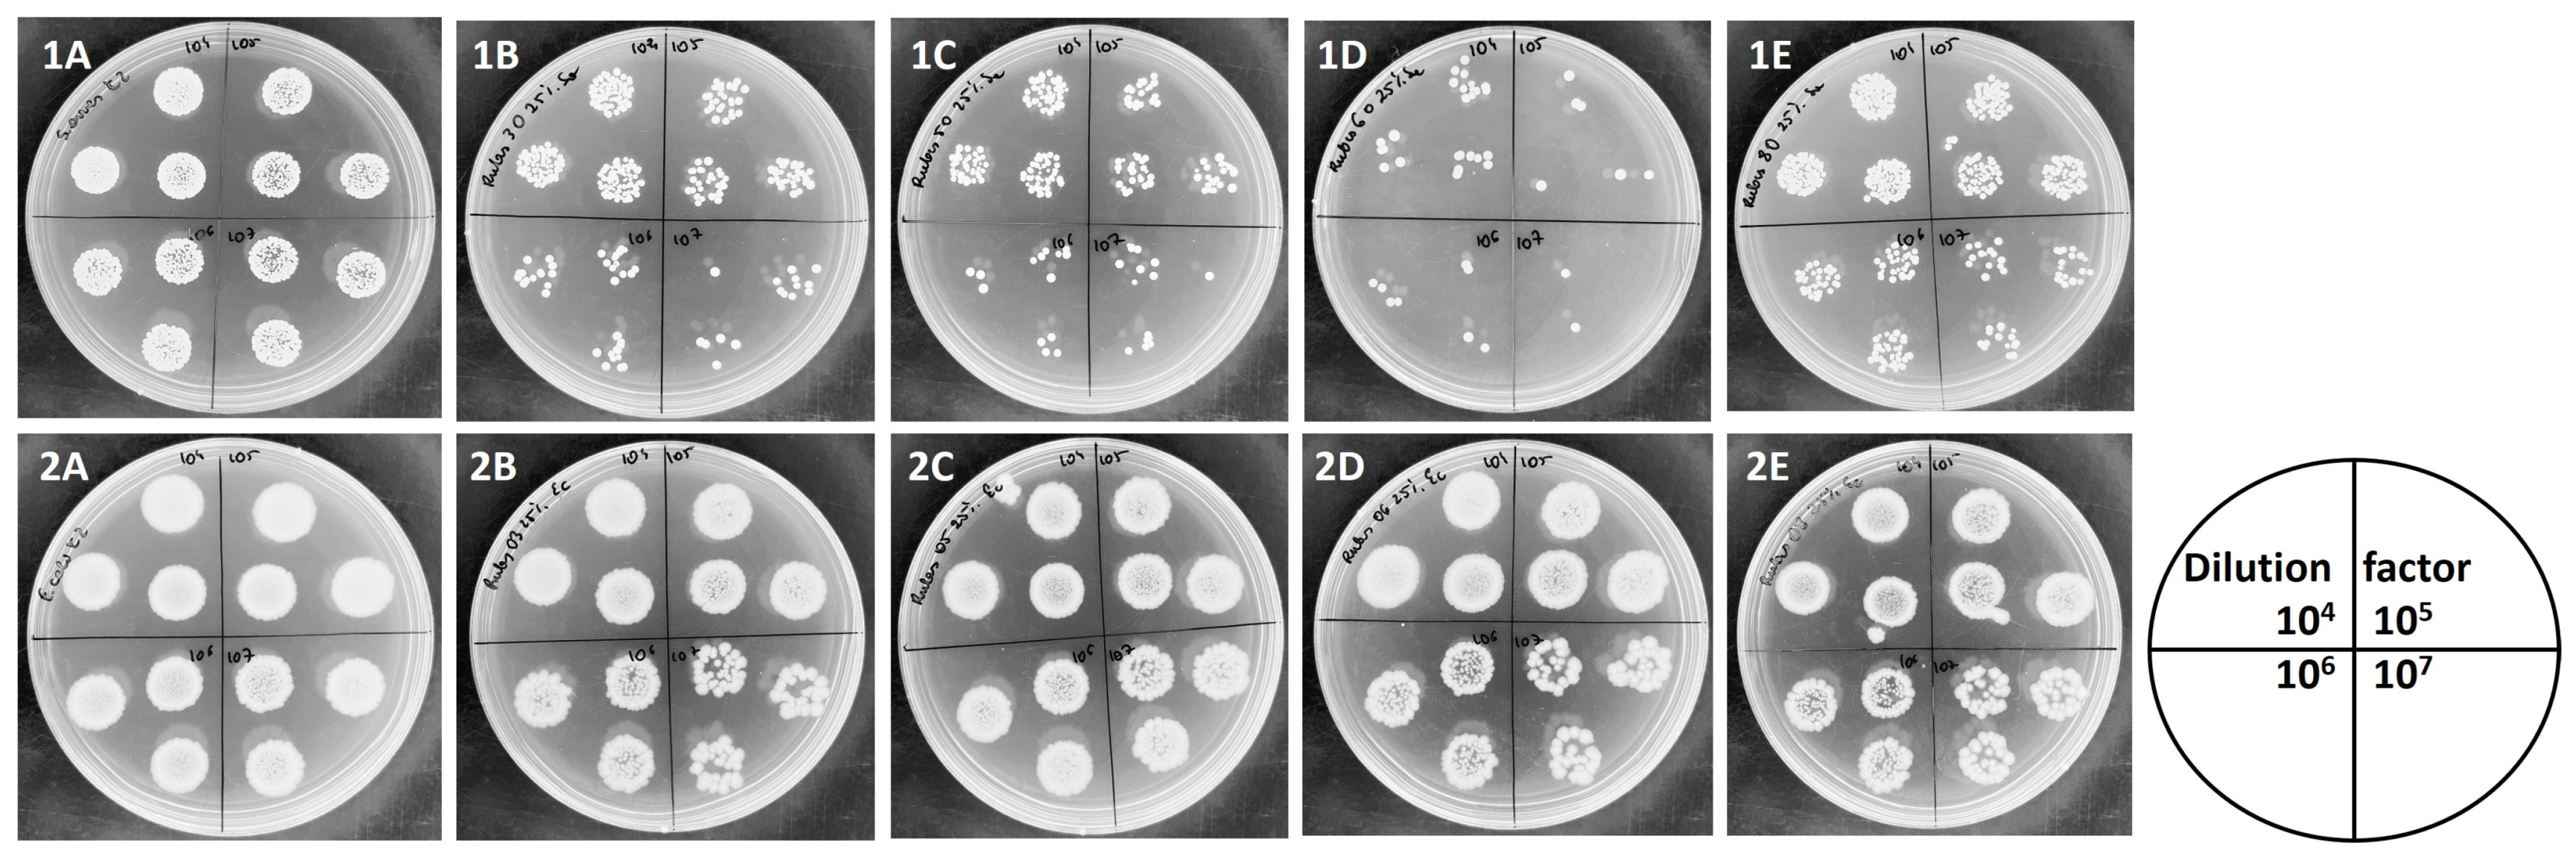

Biological Properties of Recently Described Wild Bramble Rubus oklejewiczii against the Species from Similar Niches
Abstract
1. Introduction
2. Materials and Methods
2.1. Materials
2.2. Extraction Procedure
2.3. pH Measurement
2.4. Total Phenolic Content (TPC)—Folin–Ciocalteau Method
2.5. Total Anthocyanin Content
2.6. Antioxidant Potential
2.6.1. FRAP Method
2.6.2. DPPH Method
2.6.3. Ascorbic Acid Content
2.7. Antibacterial Potential of Extracts
2.7.1. Agar Well Diffusion Method
2.7.2. Broth Dilution Method
2.8. Antiviral Potential of Extracts
2.9. Statistical Analysis
3. Results and Discussion
3.1. pH Value
3.2. Polyphenolic Content and Antioxidant Properties
3.3. Antibacterial Properties
3.3.1. Agar Well Diffusion Method
3.3.2. Broth Dilution Method
Antibacterial Properties of Leaf Extracts
Antibacterial Potential of Fruit Extracts
3.4. Antiviral Potential
3.4.1. Antivivral Potential of Leaf Extracts
3.4.2. Antiviral Potential of Fruit Extracts
3.5. Ploidy Level and Biological Properties
4. Conclusions
Author Contributions
Funding
Institutional Review Board Statement
Informed Consent Statement
Data Availability Statement
Conflicts of Interest
References
- Oklejewicz, K.; Łuczaj, Ł. Folk taxonomy of Rubus species in Poland. Ludowe Nazewnictwo i Klasyfikacja rodzaju Rubus (malina i jeżyna) w Polsce. In Dzikie Rośliny Jadalne—Zapomniany Potencjał Przyrody—Materiały z Konferencji, Przemyśl—Bolestraszyce 13 września 2007 r.; Łuczaj, Ł., Ed.; Arboretum i Zakład Fizjografii w Bolestraszycach: Bolestraszyce, Poland, 2008; pp. 201–217. (In Polish) [Google Scholar]
- Kostecka-Gugała, A.; Ledwozyw-Smoleń, I.; Augustynowicz, J.; Wyzgolik, G.; Kruczek, M.; Kaszycki, P. Antioxidant properties of fruits of raspberry and blackberry grown in central Europe. Open Chem. 2015, 13, 1313–1325. [Google Scholar] [CrossRef]
- Grabek-Lejko, D. Exploiting the antioxidant, anti-inflammatory, antimicrobial and anticancer potential of Rubus species. CAB Rev. Perspect. Agric. Vet. Sci. Nutr. Nat. Resour. 2015, 10, 201510014. [Google Scholar] [CrossRef]
- Grabek-Lejko, D.; Miłek, M.; Sidor, E.; Puchalski, C.; Dżugan, M. Antiviral and Antibacterial Effect of Honey Enriched with Rubus spp. as a Functional Food with Enhanced Antioxidant Properties. Molecules 2022, 27, 4859. [Google Scholar] [CrossRef] [PubMed]
- Bhatt, S.C.; Naik, B.; Kumar, V.; Gupta, A.K.; Kumar, S.; Preet, M.S.; Sharma, N.; Rustagi, S. Untapped potential of non-conventional rubus species: Bioactivity, nutrition, and livelihood opportunities. Plant Methods 2023, 19, 114. [Google Scholar] [CrossRef] [PubMed]
- Gil-Martínez, L.; Mut-Salud, N.; Ruiz-García, J.A.; Falcón-Piñeiro, A.; Maijó-Ferré, M.; Baños, A.; De la Torre-Ramírez, J.M.; Guillamón, E.; Verardo, V.; Gómez-Caravaca, A.M. Phytochemicals Determination, and Antioxidant, Antimicrobial, Anti-Inflammatory and Anticancer Activities of Blackberry Fruits. Foods 2023, 12, 1505. [Google Scholar] [CrossRef] [PubMed]
- Oszmiański, J.; Wojdyło, A.; Nowicka, P.; Teleszko, M.; Cebulak, T.; Wolanin, M. Determination of phenolic compounds and antioxidant activity in leaves from wild Rubus L. species. Molecules 2015, 20, 4951–4966. [Google Scholar] [CrossRef] [PubMed]
- Oszmiański, J.; Nowicka, P.; Teleszko, M.; Wojdyło, A.; Cebulak, T.; Oklejewicz, K. Analysis of Phenolic Compounds and Antioxidant Activity in Wild Blackberry Fruits. Int. J. Mol. Sci. 2015, 16, 14540–14553. [Google Scholar] [CrossRef]
- Kurtto, A.; Weber, H.E.; Lampinen, R.; Sennikov, A.N. (Eds.) Atlas Florae Europaeae. Distribution of vascular plants in Europe 15. Rosaceae (Rubus); The Committee for Mapping the Flora of Europea & Societas Biologica Fennica Vanamo: Helsinki, Finland, 2010; 362p. [Google Scholar]
- Kosiński, P.; Maliński, T.; Nobis, M.; Rojek-Jelonek, M.; Tomaszewski, D.; Dering, M.; Zieliński, J. Rubus kaznowskii (Rosaceae), a new bramble species from south-central Poland. PhytoKeys 2021, 185, 27–41. [Google Scholar] [CrossRef]
- Wolanin, M.; Musiał, K.; Nobis, M. Rubus oklejewiczii (Rosaceae), a new bramble species from Central Europe (Poland: Carpathians). Phytotaxa 2020, 438, 3. [Google Scholar] [CrossRef]
- Madani, H.; Escrich, A.; Hosseini, B.; Sanchez-Muñoz, R.; Khojasteh, A.; Palazon, J. Effect of Polyploidy Induction on Natural Metabolite Production in Medicinal Plants. Biomolecules 2021, 11, 899. [Google Scholar] [CrossRef]
- De Jesus-Gonzalez, L.; Weathers, P.J. Tetraploid Artemisia annua hairy roots produce more artemisinin than diploids. Plant Cell Rep. 2003, 21, 809–813. [Google Scholar] [CrossRef] [PubMed]
- Zieliński, J. The genus Rubus (Rosaceae) in Poland. Pol. Bot. Stud. 2004, 16, 1–300. [Google Scholar]
- Oklejewicz, K. Distribution patterns of Rubus species (Rosaceae) in the eastern part of the Polish Carpathians. Pol. Bot. Stud. 2006, 21, 1–98. [Google Scholar]
- Approved Standard NCCLS Publication M2-A5; Performance Standards for Antimicrobial Disc Suspectibility Tests. NCCLS: Villanova, PA, USA, 1993.
- Borycka, K.; Grabek-Lejko, D.; Kasprzyk, I. Antioxidant and antibacterial properties of commercial bee pollen products. J. Apicult. Res. 2015, 54, 491–502. [Google Scholar] [CrossRef]
- Sowa, P.; Grabek-Lejko, D.; Wesołowska, M.; Swacha, S.; Dżugan, M. Hydrogen peroxide-dependent antibacterial action of Melilotus albus honey. Lett. Appl. Microbiol. 2017, 65, 82–89. [Google Scholar] [CrossRef] [PubMed]
- Gündoğdu, M.; Kan, T.; Canan, İ. Bioactive and antioxidant characteristics of blackberry cultivars from East Anatolia. Turkish J. Agric. For. 2016, 40, 344–351. [Google Scholar] [CrossRef]
- Memete, A.R.; Sărac, I.; Teusdea, A.C.; Budău, R.; Bei, M.; Vicas, S.I. Bioactive Compounds and Antioxidant Capacity of Several Blackberry (Rubus spp.) Fruits Cultivars Grown in Romania. Horticulturae 2023, 9, 556. [Google Scholar] [CrossRef]
- Pantelidis, G.E.; Vasilakakis, M.; Manganaris, G.A.; Diamantidis, G. Antioxidant capacity, phenol, anthocyanin and ascorbic acid contents in raspberries, blackberries, red currants, gooseberries and Cornelian cherries. Food Chem. 2007, 102, 777–783. [Google Scholar] [CrossRef]
- Shevchuk, L.; Hrynyk, I.; Levchuk, L.; Babenko, S.; Hrynyk, R. Content of sugar, titrated acids and biologically active substances in blackberries grown in the forest-steppe of Ukraine. Acta Hortic. Regiotect. 2023, 26, 1–8. [Google Scholar] [CrossRef]
- Manso, T.; Lores, M.; de Miguel, T. Antimicrobial Activity of Polyphenols and Natural Polyphenolic Extracts on Clinical Isolates. Antibiotics 2022, 11, 46. [Google Scholar] [CrossRef]
- Efenberger-Szmechtyk, M.; Nowak, A.; Czyzowska, A. Plant extracts rich in polyphenols: Antibacterial agents and natural preservatives for meat and meat products. Crit. Rev. Food Sci. Nutr. 2021, 61, 149–178. [Google Scholar] [CrossRef]
- González, O.A.; Escamilla, C.; Danaher, R.J.; Dai, J.; Ebersole, J.L.; Mumper, R.J.; Miller, C.S. Antibacterial effects of blackberry extract target periodontopathogens. J. Periodontal Res. 2013, 48, 80–86. [Google Scholar] [CrossRef]
- Jazić, M.R.; Vulić, J.J.; Kukrić, Z.Z.; Topalić-Trivunović, L.N.; Savić, A.V. Chemical composition, biological potentials and antimicrobial activity of wild and cultivated blackberries. Acta Period. Technol. 2018, 49, 65–79. [Google Scholar] [CrossRef]
- Cisowska, A.; Wojnicz, D.; Hendrich, A.B. Anthocyanins as antimicrobial agents of natural plant origin. Nat. Prod. Commun. 2011, 6, 149–156. [Google Scholar] [CrossRef]
- Ma, Y.; Ding, S.; Fei, Y.; Liu, G.; Jang, H.; Fang, J. Antimicrobial activity of anthocyanins and catechins against foodborne pathogens Escherichia coli and Salmonella. Food Control 2019, 106, 106712. [Google Scholar] [CrossRef]
- Salamon, I.; Sezer, E.N.Ş.; Kryvtsova, M.; Labun, P. Antiproliferative and antimicrobial activity of anthocyanins from berry fruits after their isolation and freeze-drying. Appl. Sci. 2021, 11, 2096. [Google Scholar] [CrossRef]
- Muniyandi, K.; George, E.; Sathyanarayanan, S.; George, B.P.; Abrahamse, H.; Thamburaj, S.; Thangaraj, P. Phenolics, tannins, flavonoids and anthocyanins contents influenced antioxidant and anticancer activities of Rubus fruits from Western Ghats, India. Food Sci. Hum. Wellness 2019, 8, 73–81. [Google Scholar] [CrossRef]
- Deighton, N.; Brennan, R.; Finn, C.; Davies, H.V. Antioxidant properties of domesticated and wild Rubus species. J. Sci. Food Agric. 2000, 80, 1307–1313. [Google Scholar] [CrossRef]
- Suriyaprom, S.; Mosoni, P.; Leroy, S.; Kaewkod, T.; Desvaux, M.; Tragoolpua, Y. Antioxidants of Fruit Extracts as Antimicrobial Agents against Pathogenic Bacteria. Antioxidants 2022, 11, 602. [Google Scholar] [CrossRef]
- Tajkarimi, M.; Salam, A.; Ibrahim, S.A. Antimicrobial activity of ascorbic acid alone or in combination with lactic acid on Escherichia coli O157:H7 in laboratory medium and carrot juice. Food Control 2011, 22, 801–804. [Google Scholar] [CrossRef]
- Rocabado, G.O.; Bedoya, L.M.; Abad, M.J.; Bermejo, P. Rubus—A review of its phytochemical and pharmacological profile. Nat. Prod. Commun. 2008, 3, 423–436. [Google Scholar] [CrossRef]
- Radovanovi´c, B.C.; Andelkovi´c, A.S.M.; Radovanovi´c, A.B.; Andelkovi´c, M.Z. Antioxidant and Antimicrobial Activity of Polyphenol Extracts from Wild Berry Fruits Grown in Southeast Serbia. Trop. J. Pharm. Res. 2013, 12, 813–819. [Google Scholar]
- Kowalczyk, M.; Golonko, A.; Świsłocka, R.; Kalinowska, M.; Parcheta, M.; Swiergiel, A.; Lewandowski, W. Drug Design Strategies for the Treatment of Viral Disease. Plant Phenolic Compounds and Their Derivatives. Front Pharmacol. 2021, 30, 709104. [Google Scholar] [CrossRef]
- Lin, Q.; Lim, J.Y.C.; Xue, K.; Yin, P.; Yew, M.; Owh, C.; Chee, P.L.; Loh, X.J. Sanitizing agents for virus inactivation and disinfection. View 2020, 1, e16. [Google Scholar] [CrossRef]
- Ranveer, S.A.; Dasriya, V.; Ahmad, M.F.; Dhillon, H.S.; Samtiya, M.; Shama, E.; Anand, T.; Dhewa, T.; Chaudhary, V.; Chaudhary, P.; et al. Positive and negative aspects of bacteriophages and their immense role in the food chain. NPJ Sci. Food 2024, 8, 1. [Google Scholar] [CrossRef]
- Szafrańska, A.K.; Junker, V.; Steglich, M.; Nübel, U. Rapid cell division of Staphylococcus aureus during colonization of the human nose. BMC Genom. 2019, 20, 229. [Google Scholar] [CrossRef]
- Colunga Biancatelli, R.M.L.; Berrill, M.; Catravas, J.D.; Marik, P.E. Quercetin and Vitamin C: An Experimental, Synergistic Therapy for the Prevention and Treatment of SARS-CoV-2 Related Disease (COVID-19). Front. Immunol. 2020, 11, 1451. [Google Scholar] [CrossRef]
- Grudlewska-Buda, K.; Wiktorczyk-Kapischke, N.; Budzyńska, A.; Kwiecińska-Piróg, J.; Przekwas, J.; Kijewska, A.; Sabiniarz, D.; Gospodarek-Komkowska, E.; Skowron, K. The Variable Nature of Vitamin C—Does It Help When Dealing with Coronavirus? Antioxidants 2022, 11, 1247. [Google Scholar] [CrossRef]
- Serrano-Aroca, Á. Antiviral Characterization of Advanced Materials: Use of Bacteriophage Phi 6 as Surrogate of Enveloped Viruses Such as SARS-CoV-2. Int. J. Mol. Sci. 2022, 23, 5335. [Google Scholar] [CrossRef]
- Bertea, C.M.; Azzolin, C.M.M.; Bossi, S.; Doglia, G.; Maffei, M.E. Identification of an EcoRI restriction site for a rapid and precise determination of β-asarone-free Acorus calamus cytotypes. Phytochemistry 2005, 66, 507–514. [Google Scholar] [CrossRef]
- Ravandi, E.G.; Rezanejad, F.; Zolala, J.; Dehghan, E. The effects of chromosome-doubling on selected morphological and phytochemical characteristics of Cichorium intybus L. J. Hortic. Sci. Biotechnol. 2015, 88, 701–709. [Google Scholar] [CrossRef]
- Meng, Q.; Manghwar, H.; Hu, W. Study on Supergenus Rubus L.: Edible, Medicinal, and Phylogenetic Characterization. Plants 2022, 11, 1211. [Google Scholar] [CrossRef] [PubMed]
- Mohammadpour, S.; Karimzadeh, G.; Ghaffari, S.M. Karyomorphology, genome size, and variation of antioxidant in twelve berry species from Iran. Caryologia 2022, 75, 133–148. [Google Scholar] [CrossRef]
- Sabooni, N.; Gharaghani, A. Induced polyploidy deeply influences reproductive life cycles, related phytochemical features, and phytohormonal activities in blackberry species. Front Plant Sci. 2022, 13, 938284. [Google Scholar] [CrossRef] [PubMed]
- Li, J.; Hoshino, Y. Elucidating the impact of ploidy level on biochemical content accumulation in haskap (Lonicera caerulea L. subsp. edulis (Turcz. ex Herder) Hultén) fruits: A comprehensive approach for fruit assessment. Sci. Hortic. 2024, 327, 11283. [Google Scholar] [CrossRef]
- Fujita, R.; Jin, S.; Matoba, K.; Hoshino, Y. Novel production of β-cryptoxanthin in haskap (Lonicera caerulea subsp. edulis) hybrids: Improvement of carotenoid biosynthesis by interspecific hybridization. Sci. Hortic. 2023, 308, 111547. [Google Scholar] [CrossRef]
- Mengist, M.F.; Grace, M.H.; Xiong, J.; Kay, C.D.; Bassil, N.; Hummer, K.; Ferruzzi, M.G.; Lila, M.A.; Iorizzo, M. Diversity in Metabolites and Fruit Quality Traits in Blueberry Enables Ploidy and Species Differentiation and Establishes a Strategy for Future Genetic Studies. Front. Plant Sci. 2020, 11, 370. [Google Scholar] [CrossRef]
- Hassanzadeh, F.; Zakaria, R.A.; Azad, N.H. Polyploidy induction in Salvia officinalis L. And its effects on some morphological and physiological characteristics. Cytologia 2020, 85, 157–162. [Google Scholar] [CrossRef]
- Allario, T.; Brumos, J.; Colmenero-Flores, J.M.; Tadeo, F.; Froelicher, Y.; Talon, M.; Navarro, L.; Ollitrault, P.; Morillon, R. Large changes in anatomy and physiology between diploid Rangpur lime (Citrus limonia) and its autotetraploid are not associated with large changes in leaf gene expression. J. Exp. Bot. 2011, 62, 2507–2519. [Google Scholar] [CrossRef]
- Iannicelli, J.; Guariniello, J.; Tossi, V.E.; Regalado, J.J.; Di Ciaccio, L.; van Baren, C.M.; Pitta Álvarez, S.I.; Escandón, A.S. The “polyploid effect” in the breeding of aromatic and medicinal species. Sci. Hortic. 2020, 260, 108854. [Google Scholar] [CrossRef]

| Species | Voucher Specimens Number | Ploidy Level | Geographical Location | Time of Harvesting | |
|---|---|---|---|---|---|
| R. plicatus | 003724a,b | 4x | Piątkowa | N 49°52′53.6″; E 022°08′ 11.3″ | 19.07.2022 |
| R. wimmerianus | 003710a,b | 4x | Lecka–Wilczak | N 49°53′12.0″; E 22°01′ 09.2″ | 26.07.2022 |
| R. gracilis | 003711a,b | 4x | Lecka–Wilczak | N 49°53′12.9″; E 22°01′ 10.0″ | 26.07.2022 |
| R. oklejewiczii | 003705a,b | 5x | Kąkolówka–Wola | N 49°51′16.5″; E 22°01′ 39.8″ | 28.07.2022 |
| Blackberry Extract | Leaf Extracts | Fruit Extracts | ||||||
|---|---|---|---|---|---|---|---|---|
| TPC (µg/mL) | DPPH (µmol/mL) | FRAP (µmol/mL) | TPC (µg/mL) | TAC (µg/mL) | DPPH (µmol/mL) | FRAP (µmol/mL) | AA (µg/mL) | |
| R. plicatus | 1026.67 ± 42.59 c | 41.34 ± 0.66 b | 12.92 ± 1.13 c | 119.44 ± 6.38 c | 113.86 ± 0.47 d | 9.71 ± 1.00 a | 1.69 ± 0.04 d | 268 ± 11 a |
| R. wimmerianus | 1097.22 ± 42.80 d | 42.08 ± 0.06 b | 13.56 ± 1.34 c | 105.00 ± 2.13 bc | 105.85 ± 6.14 c | 12.24 ± 0.66 b | 1.53 ± 0.09 c | 302 ± 8 b |
| R. gracilis | 805.00 ± 19.40 b | 41.94 ± 0.15 b | 10.31 ± 0.80 b | 98.89 ± 2.22 b | 69.28 ± 2.60 a | 10.94 ± 0.80 a | 1.41 ± 0.05 b | 292 ± 20 ab |
| R. oklejewiczii | 271.11 ± 5.13 a | 24.05 ± 0.75 a | 1.87 ± 0.13 a | 80.00 ± 15.71 a | 76.13 ± 0.94 b | 11.71 ± 0.21 b | 1.01 ± 0.02 a | 328 ± 27 b |
| Rubus | Leaf Extracts | Fruit Extracts | ||||||
|---|---|---|---|---|---|---|---|---|
| Gram-Positive | Gram-Negative | Gram-Positive | Gram-Negative | |||||
| S.a | B.c | E.c | S.e | S.a | B.c | E.c | S.e | |
| R. plicatus | 21 ± 0.14 b | 17 ± 0.06 c | 15 ± 0.07 d | 14 ± 0.07 c | 13 ± 0.14 b | 12 ± 0.10 b | 15 ± 0.18 b | 11 ± 0.07 b |
| R. wimmerianus | 22 ± 0.00 c | 17 ± 0.07 c | 12 ± 0.12 b | 15 ± 0.04 d | 14 ± 0.10 c | 11 ± 0.12 a | 15 ± 0.00 b | 11 ± 0.00 b |
| R. gracilis | 23 ± 0.07 d | 15 ± 0.21 b | 13 ± 0.07 c | 13 ± 0.08 b | 14 ± 0.12 c | 15 ± 0.14 d | 18 ± 0.20 c | 15 ± 0.06 c |
| R. oklejewiczii | 12 ± 0.07 a | 10 ± 0.00 a | 10 ± 0.00 a | 10 ± 0.00 a | 10 ± 0.00 a | 13 ± 0.50 c | 10 ± 0.00 a | 10 ± 0.00 a |
| Ampicillin | 45 ± 0.00 | 19 ± 1.2 | 40 ± 0.22 | 40 ± 0.24 | - | - | - | - |
| Streptomycin | 35 ± 0.00 | 35 ± 2.3 | 35 ± 0.25 | 40 ± 0.32 | - | - | - | - |
| Water | 10 ± 0.00 | 10 ± 0.00 | 10 ± 0.00 | 10 ± 0.00 | 10 ± 0.00 | 10 ± 0.00 | 10 ± 0.00 | 10 ± 0.00 |
Disclaimer/Publisher’s Note: The statements, opinions and data contained in all publications are solely those of the individual author(s) and contributor(s) and not of MDPI and/or the editor(s). MDPI and/or the editor(s) disclaim responsibility for any injury to people or property resulting from any ideas, methods, instructions or products referred to in the content. |
© 2024 by the authors. Licensee MDPI, Basel, Switzerland. This article is an open access article distributed under the terms and conditions of the Creative Commons Attribution (CC BY) license (https://creativecommons.org/licenses/by/4.0/).
Share and Cite
Grabek-Lejko, D.; Wolanin, M.; Szpytma, A.; Pajda, D.; Miłek, M.; Puchalski, C. Biological Properties of Recently Described Wild Bramble Rubus oklejewiczii against the Species from Similar Niches. Foods 2024, 13, 337. https://doi.org/10.3390/foods13020337
Grabek-Lejko D, Wolanin M, Szpytma A, Pajda D, Miłek M, Puchalski C. Biological Properties of Recently Described Wild Bramble Rubus oklejewiczii against the Species from Similar Niches. Foods. 2024; 13(2):337. https://doi.org/10.3390/foods13020337
Chicago/Turabian StyleGrabek-Lejko, Dorota, Mateusz Wolanin, Aleksandra Szpytma, Danuta Pajda, Michał Miłek, and Czesław Puchalski. 2024. "Biological Properties of Recently Described Wild Bramble Rubus oklejewiczii against the Species from Similar Niches" Foods 13, no. 2: 337. https://doi.org/10.3390/foods13020337
APA StyleGrabek-Lejko, D., Wolanin, M., Szpytma, A., Pajda, D., Miłek, M., & Puchalski, C. (2024). Biological Properties of Recently Described Wild Bramble Rubus oklejewiczii against the Species from Similar Niches. Foods, 13(2), 337. https://doi.org/10.3390/foods13020337

